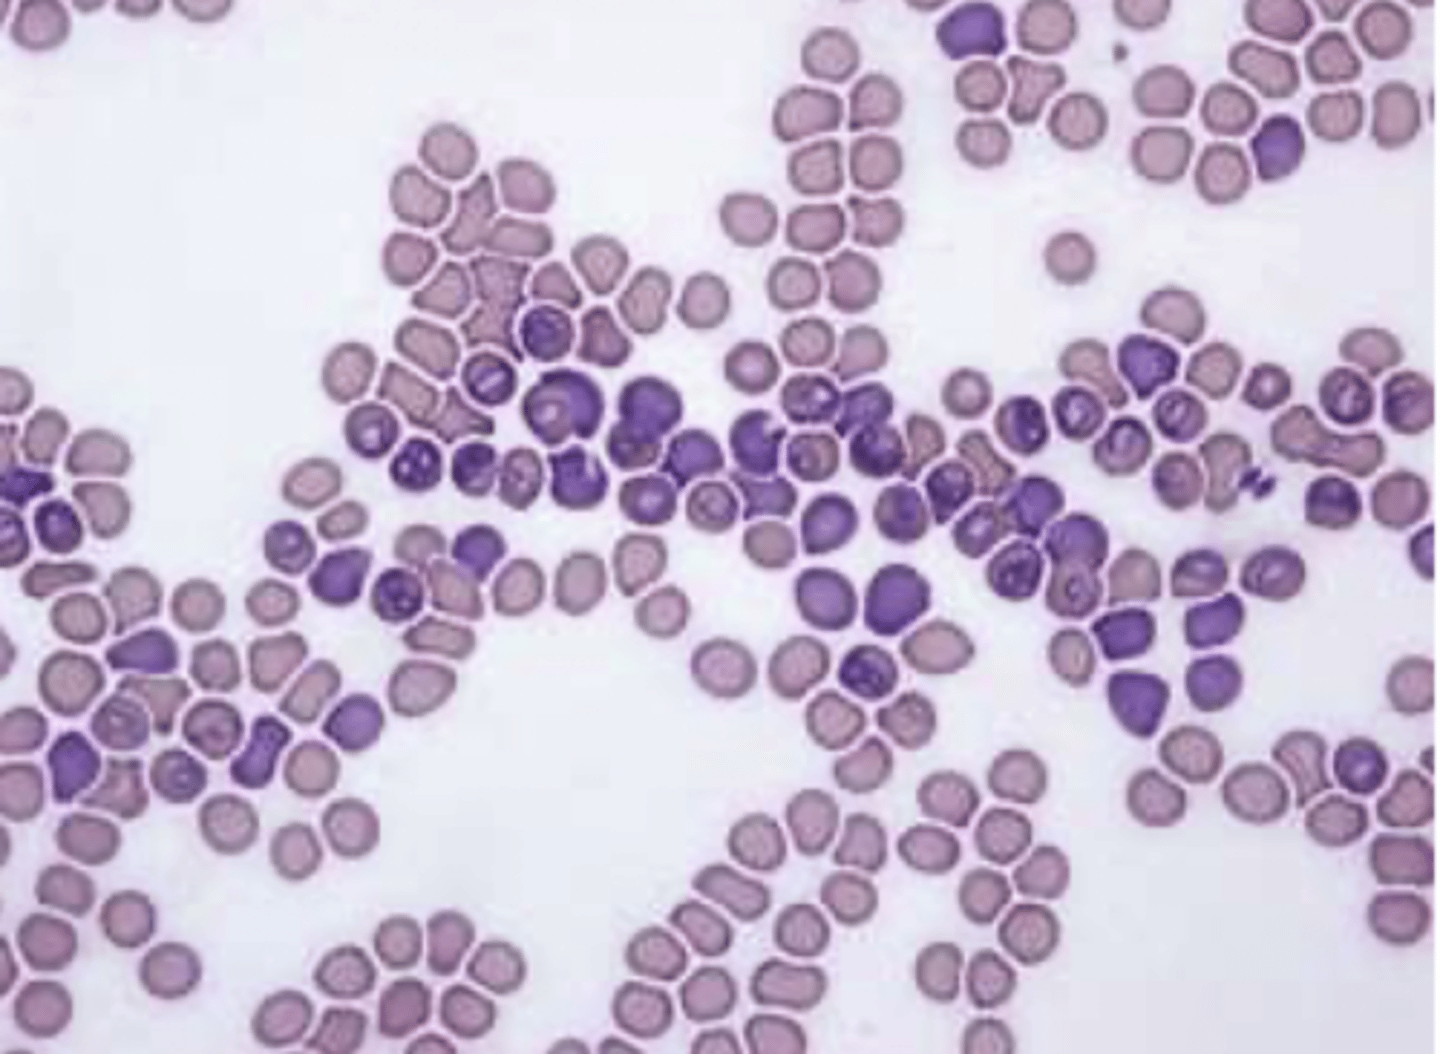
<p>interpretar esta muestra de sangre:</p>

1/95
Looks like no tags are added yet.
Name | Mastery | Learn | Test | Matching | Spaced | Call with Kai |
|---|
No analytics yet
Send a link to your students to track their progress
PV x dosis / concentración (mg/ml)
ej: peso 32 kg, dosis 1mg, concentración 20mg/ml → 1.6ml
¿cómo hacemos el cálculo de dosis para medicinas inyectables?
1.6 ml
(32 x 1 / 20)
tenemos un perro de 32kg.
queremos inyectar un fármaco de concentración 20mg/ml, con un dosis de 1mg/kg.
¿cuánto ponemos?
1. nombre del fármaco + principio activo
2. clase de prescripción (ordinaria o excepcional)
3. indicación para la que se prescribe
4. forma farmaceútica + concentración
5. cantidad/# de envases
6. regimen posológico, con indicación de la vía de administración, dosis y duración del tto
¿cómo formulamos una receta?

anemia regenerativa
hemólisis (por valor de PTT normal)
+ trombocitopenia
¿anemia regenerativa o no regenerativa?
¿causa de anemia?

perros: >60,000
gatos: >50,000
una anemia es regenerativa si el # de reticulocitos es:
PTT:
normal → hemólisis
↓ → hemorragia
¿en qué parámetro enfocamos para ver si la anemia regenerativa es por hemorragia o hemólisis?
deshidratación
un aumento de los PTT nos indica:
leucocitosis neutrofílica, con desviación izquierda, regenerativa.
= inflamación aguda
nombrar los cambios en la leucograma + causa probable.

inflam. aguda
desv izquierda: ↑ banda
regenerativa: segmentados > banda
¿qué es una leucocitosis neutrofílica, con desviación izquierda, regenerativa?
fisiológica: excitación, miedo, ejercicio (+ linfocitosis)
estrés: + linfopenia
desv derecha: ↑ segmentados, sin cambios de banda.
¿qué es una leucocitosis neutrofílica, con desviación derecha?
excitación, miedo, ejercicio
- desv. derecha
- linfocitosis
¿qué es un patrón leucograma fisiológica?
- desv. derecha
- linfocitopenia
¿qué es un patrón leucograma de estrés?
fisiológica (excitación, miedo, ejercicio)
una leucograma con desviación derecha + linfocitosis es:
estrés (cortisol)
una leucograma con desviación derecha + linfocitopenia es:
inflamación aguda
una leucograma con desviación izquierda + linfocitopenia es:
inflamación crónica
una leucograma con desviación izquierda + linfocitosis es:
neutrofilica desviación izquierda + linfopenia
¿cómo aparece inflamación aguda en una leucograma?
neutrofilica desviación izquierda + linfocitosis
¿cómo aparece inflamación crónica en una leucograma?
neutrofilica desviación derecha + linfopenia
¿cómo aparece estrés en una leucograma?
neutrofílica desviación derecha + linfocitosis
¿cómo aparece excitación/ miedo/ ejercicio en una leucograma?
leucocitosis neutrofílica, desviación izquierda regenerativa
inflamación
interpretar esta leucograma:

anemia regenerativa + trombocitopenia
→ hemólisis (proteínas normales)
interpretar esta hemograma:

hemólisis (por la plasma rojo)
interpretar esta muestra de sangre:

babesiosis
interpretar esta muestra de sangre:
anemia no regenerativa, por hemorragia
leucocitosis neutrofílica desviación derecha → estrés
interpretar esta analítica:

anemia grave, no regenerativa.
leucograma normal
interpretar esta analítica:

el tamaño de los glóbulos rojos.
↑ : macrocitosis
↓ : microcitosis
¿qué nos indica VCM/MCV?
cantidad de hemoglobina por GR
↑ : hipercrómica
↓ : hipocrómica (anemia regen, o falta de hierro)
¿qué nos indica MCH/CHCM?
↑ células banda
pero todavía segmentados > banda
(infección)
¿qué es una desviación izquierda regenerativa?
↑ células banda
y segmentados < banda
(infección muy grave)
¿qué es una desviación izquierda degenerativa?
- insuficiencia renal
- deshidratación
- hemorragia digestiva
un aumento de UREA significa:
- enf. hepática
- dieta baja en proteínas
una disminución de UREA significa:
- lesión renal
- deshidratación severa
- destrucción muscular
un aumento de CREA significa:
poca masa muscular
una disminución de CREA significa:
- daño hepatocelular (hepatitis, toxicidad)
- infiltración hepática (neoplasia, lipidosis)
un aumento de ALT significa:
daño hepático O muscular
un aumento de AST significa:
- colestasis
- neoplasia hepática
- corticosteriodes
un aumento de ALP significa:
- colestasis
- hepatopatía obstructiva
- corticoides, fenobarbital
un aumento de GGT significa:
- colestasis
- hemólisis
- disfunción hepática avanzada
un aumento de bilirubina significa:
- colestasis
- shunt portosistémica
- disfunción hepática
un aumento de ácidos biliares significa:
deshidratación
un aumento de albumina significa:
- insuf. hepática
- pérdida de proteinas
- inflam. crónica
- malabsorción
una disminución de albumina significa:
- colestasis
- hipotiroidismo
- síndrome nefrótico
un aumento de colesterol significa:
- insuf. hepática
- malabsorción
- hipoadrenocorticismo
una disminución de colesterol significa:
- exceso de insulina
- sepsis
una disminución de glucosa significa:
- diabetes
- estrés
- pancreatitis
un aumento de glucosa significa:
- hemorragia
- malabsorción
- enf. hepática
una disminución de proteínas totales significa:
- deshidratación
- inflam. crónica
un aumento de albumina significa:
1
perro:
crea: <1.4
SDMA: <18
puede ser una insuficiencia renal estadio:
2
perro:
crea: 1.4-2.8
SDMA: 18- 35
puede ser una insuficiencia renal estadio:
3
perro:
crea: 2.9-5
SDMA: 36-54
puede ser una insuficiencia renal estadio:
4
perro:
crea: >5
SDMA: >54
puede ser una insuficiencia renal estadio:
1
gato:
crea: <1.6
SDMA: <18
puede ser una insuficiencia renal estadio:
2
gato:
crea: 1.6-2.8
SDMA: 18-25
puede ser una insuficiencia renal estadio:
3
gato:
crea: 2.9-5
SDMA: 26-38
puede ser una insuficiencia renal estadio:
4
gato:
crea: >5
SDMA: >38
puede ser una insuficiencia renal estadio:
<0.2
el rango normal de la proteína en orina es:
perro: >0.5
gato: >0.4
si hay _______ proteína en la orina, se considera proteinuria
límite de proteinuria
si en la orina hay 0.2-0.4 proteína, es:
<140 mmHg
la presión sistólica normal es:
normal
si un animal tiene una presión sistólica de <140mmHg, es:
prehipertensión
<140 : normal
>160 : hipertensión
si un animal tiene una presión sistólica de 140-159mmHg, es:
hipertensión
>179 : hipertensión grave
si un animal tiene una presión sistólica de 160-179mmHg, es:
>159 mmHg
160-179: hipertensión
>179: hipertensión grave
¿qué será la presión sistólica de un animal con hipertensión?
>179 mmHg
¿qué será la presión sistólica de un animal con hipertensión grave?
hipertensión grave
si un animal tiene una presión sistólica de >179mmHg, es:
perro: 1030-1035
gato: 1035-1045
¿cómo deber ser la densidad de orina normal?
hiperestenuria
(por deshidratación o shock)
si un perro tiene la densidad de orina de >1035, hay :
hiperestenuria
(por deshidratación o shock)
si un gato tiene la densidad de orina de >1045, hay :
perro: >1035
gato: >1045
un animal se considera hiperestenúrico si tiene valores de:
<1008
(enf. metabólica/endocrino)
un animal se considera hipoestenúrico si tiene valores de:
1008-1012
(insuficiencia renal)
un animal se considera isoestenúrico si tiene valores de:
1008-1012
(isoestenuria)
un animal con insuficiencia renal tendrá una concentración de la orina de:
normal: 6-7
aumento: infección, dieta vegetal
disminución: acidosis, dieta carnívora
el pH normal de la orina es:
si aumenta, indica:
si disminuye: indica:
glomerulonefritis
infección urinaria
si hay proteinuria (>0.4), nos indica:
diabetes mellitus
si hay glucosuria, nos indica:
cetosis
diabetes mal controlado
ayuno prolongado
si hay cetonuria, nos indica:
enf. hepática
hemólisis
(en perros, puede haber trazas de bilirubina en la orina)
si hay bilirubinuria, nos indica:
inflamación
infección
cálculos
tumor
si hay hematuria, nos indica:
infección
urolitiasis
toxicidad renal
si hay sedimento urinario (cilindros, cristales, células), nos indica:
sterovet
PV x 30 + 70 = ml/día
¿cuales fluidos escogemos para mantenimiento?
¿cuánto ponemos?
RL, isofundin
PV x %dh x 10 = ml/día
¿cuales fluidos escogemos para reposición?
¿cuánto ponemos?
glucosa 5%
NaCl 0.45%
¿cuales son los fluidos hipotónicos?
NaCl 7.5%
¿cuales son los fluidos hipertónicos?
RL
sterovet
★ en hepatopatía, escoger isofundin para la reposición
¿cuales fluidos contienen lactato, y por tanto, pueden ser peligrosos en pacientes hepáticos?
indetectable
un grado de deshidratación 4% presenta como:
retraso leve en la pliegue cutáneo
un grado de deshidratación 4-6% presenta como:
- retraso claro en la pliegue cutáneo
- sequedad moderada de mucosas
- leve taquicardia
un grado de deshidratación 6-8% presenta como:
- retraso grave en la pliegue cutáneo
- clara sequedad de mucosas
- hundimiento de globos oculares
- oliguria
- taquicardia
- mucosas pálidas
- pulso débil
un grado de deshidratación 8-10% presenta como:
signos de shock hipovolémico:
- taquicardia marcada
- pulso débil
- TRC >2s
- mucosas pálidas
- hipotermia
- depresión mental
un grado de deshidratación 10-12% presenta como:
signos graves de shock hipovolémico
un grado de deshidratación 12-15% presenta como:
4-6
un animal con un retraso leve en la pliegue cutáneo tiene deshidratación de ____%
6-8
un animal con:
- retraso claro en la pliegue cutáneo
- sequedad moderada de mucosas
- leve taquicardia
tiene deshidratación de ____%
8-10
un animal con:
- retraso grave en la pliegue cutáneo
- clara sequedad de mucosas
- hundimiento de globos oculares
- oliguria
- taquicardia
- mucosas pálidas
- pulso débil
tiene deshidratación de ____%
10-12
un animal con:
signos de shock hipovolémico (taquicardia marcada, pulso débil, TRC >2s, mucosas pálidas, hipotermia, depresión mental)
tiene deshidratación de ____%
12-15
un animal con:
signos muy graves de shock hipovolémico (taquicardia muy marcada, pulso débil, TRC >2s, mucosas pálidas, hipotermia grave, depresión mental)
tiene deshidratación de ____%